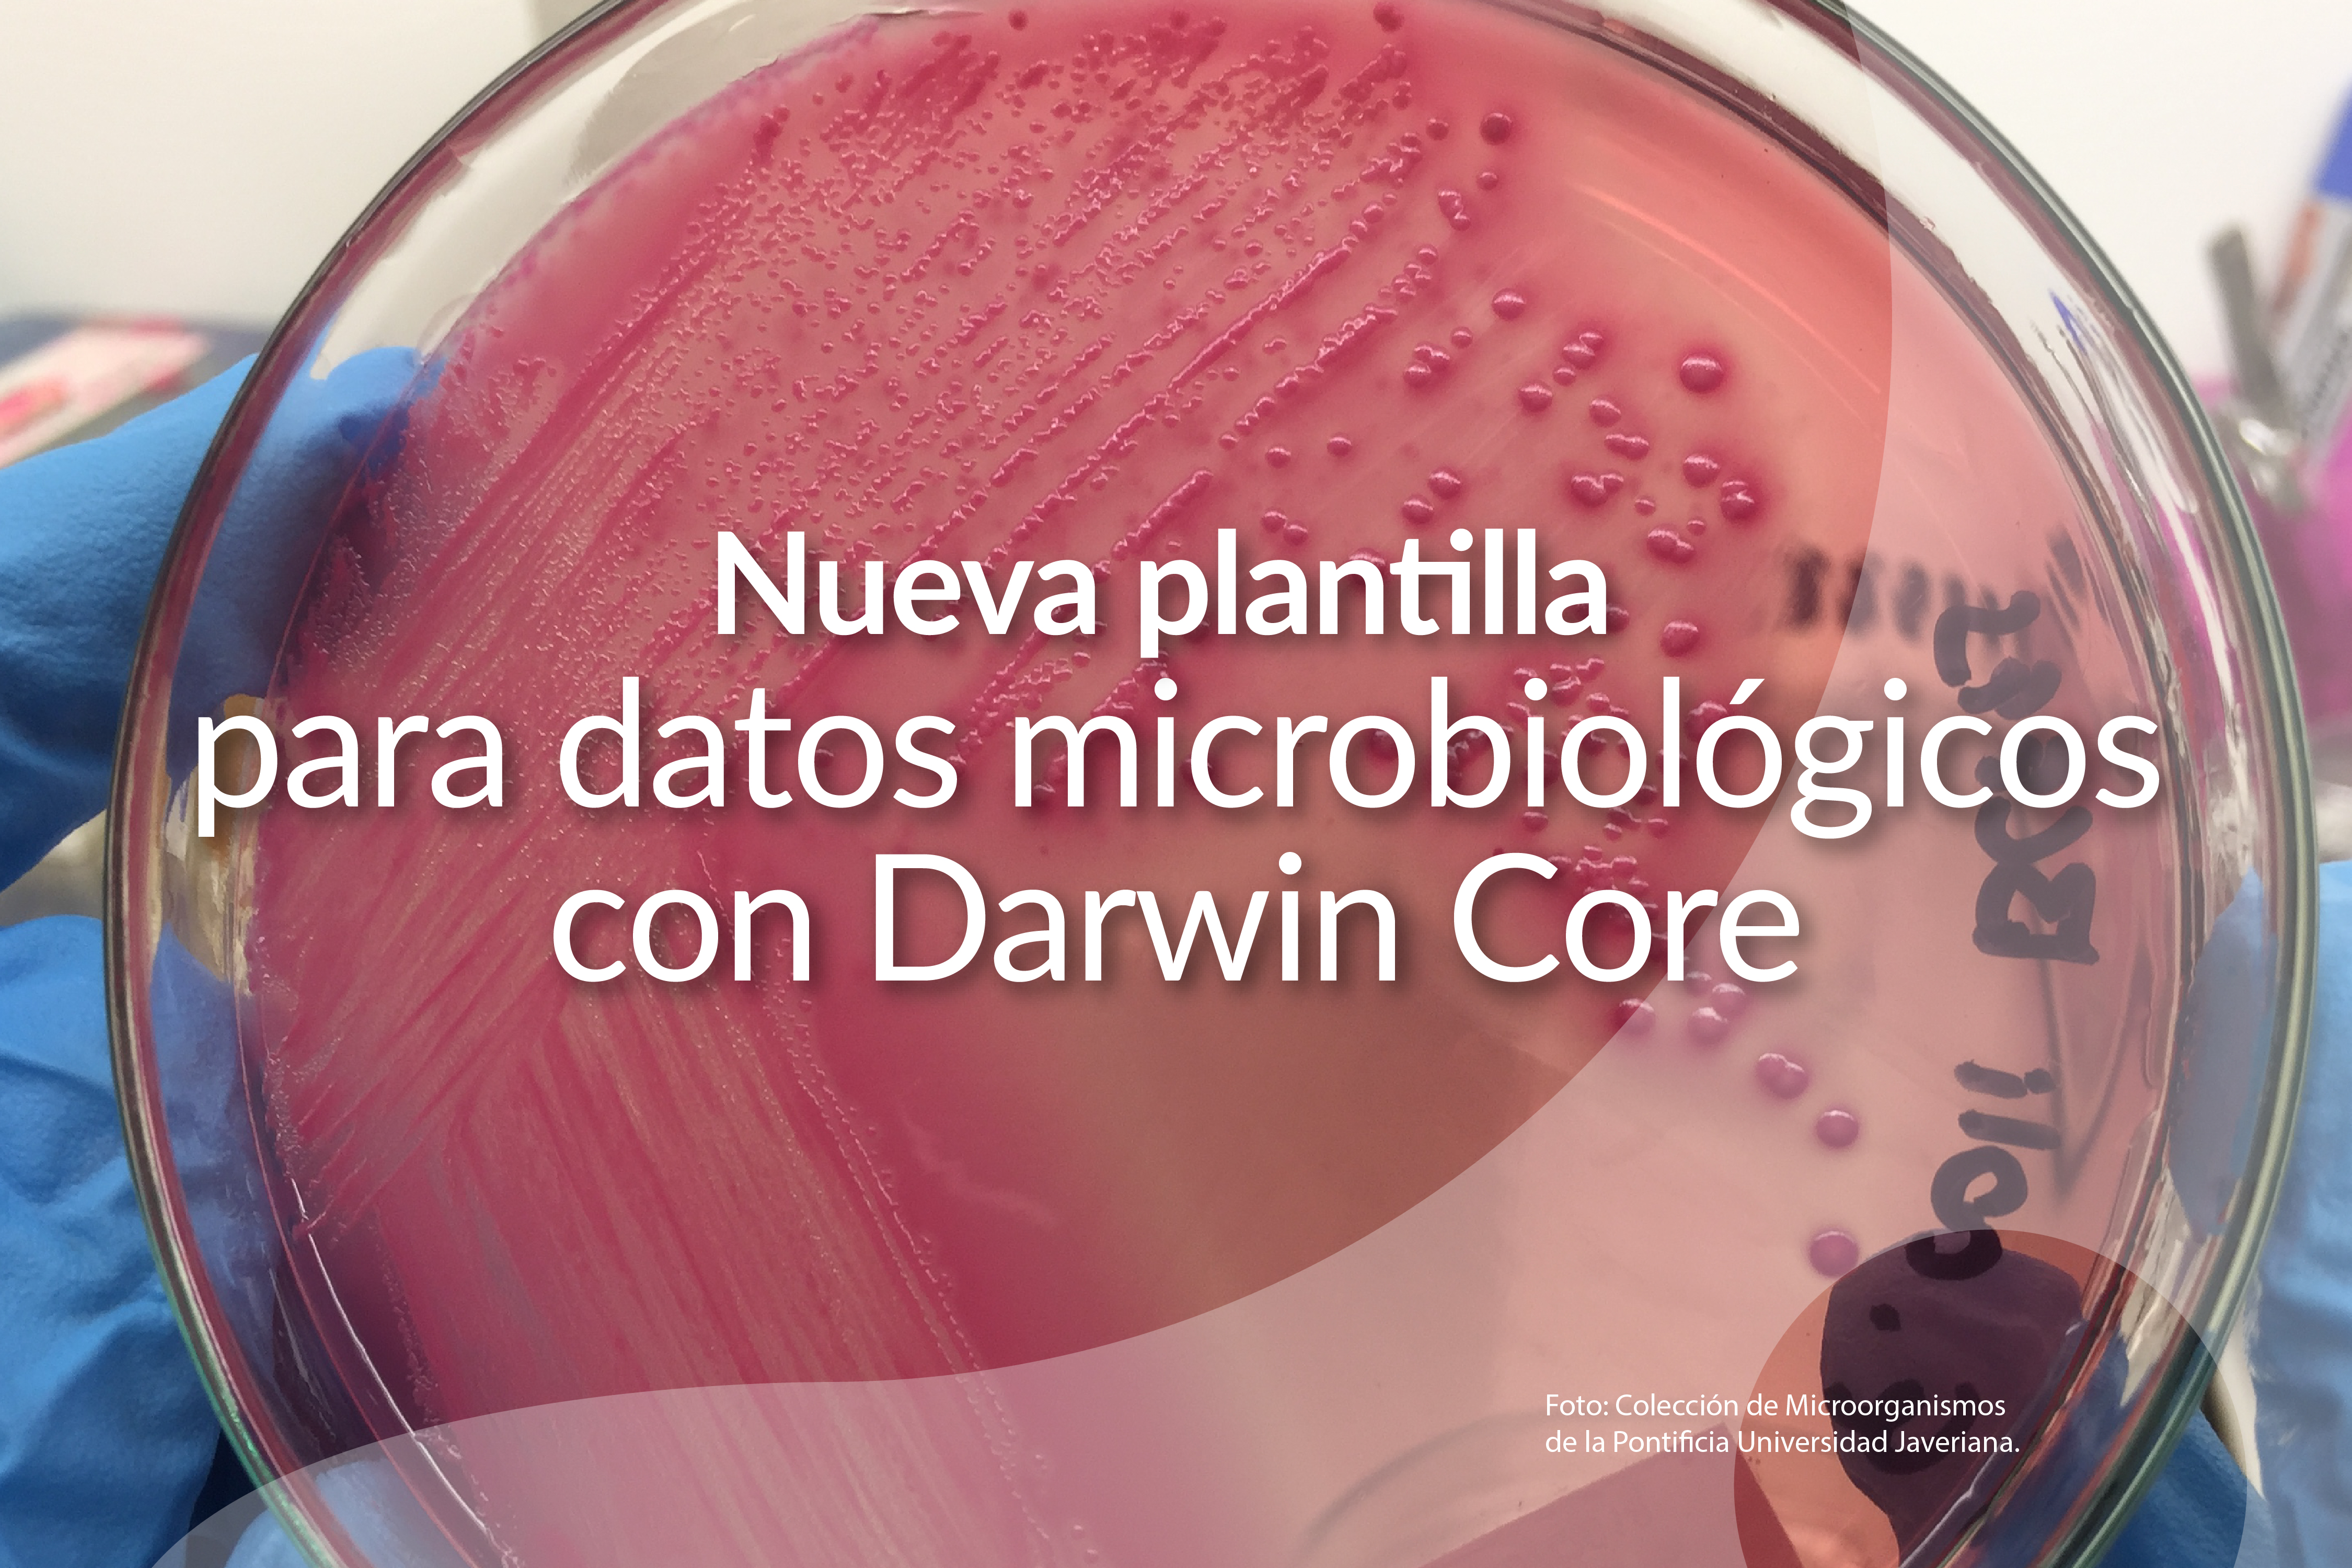

En marzo, una comunidad del Meta y una universidad de Medellín ampliaron el mapa de la biodiversidad colombiana.
Durante marzo de 2026, el SiB Colombia sumó nuevos aliados y nuevos datos abiertos sobre la biodiversidad del país. Este…